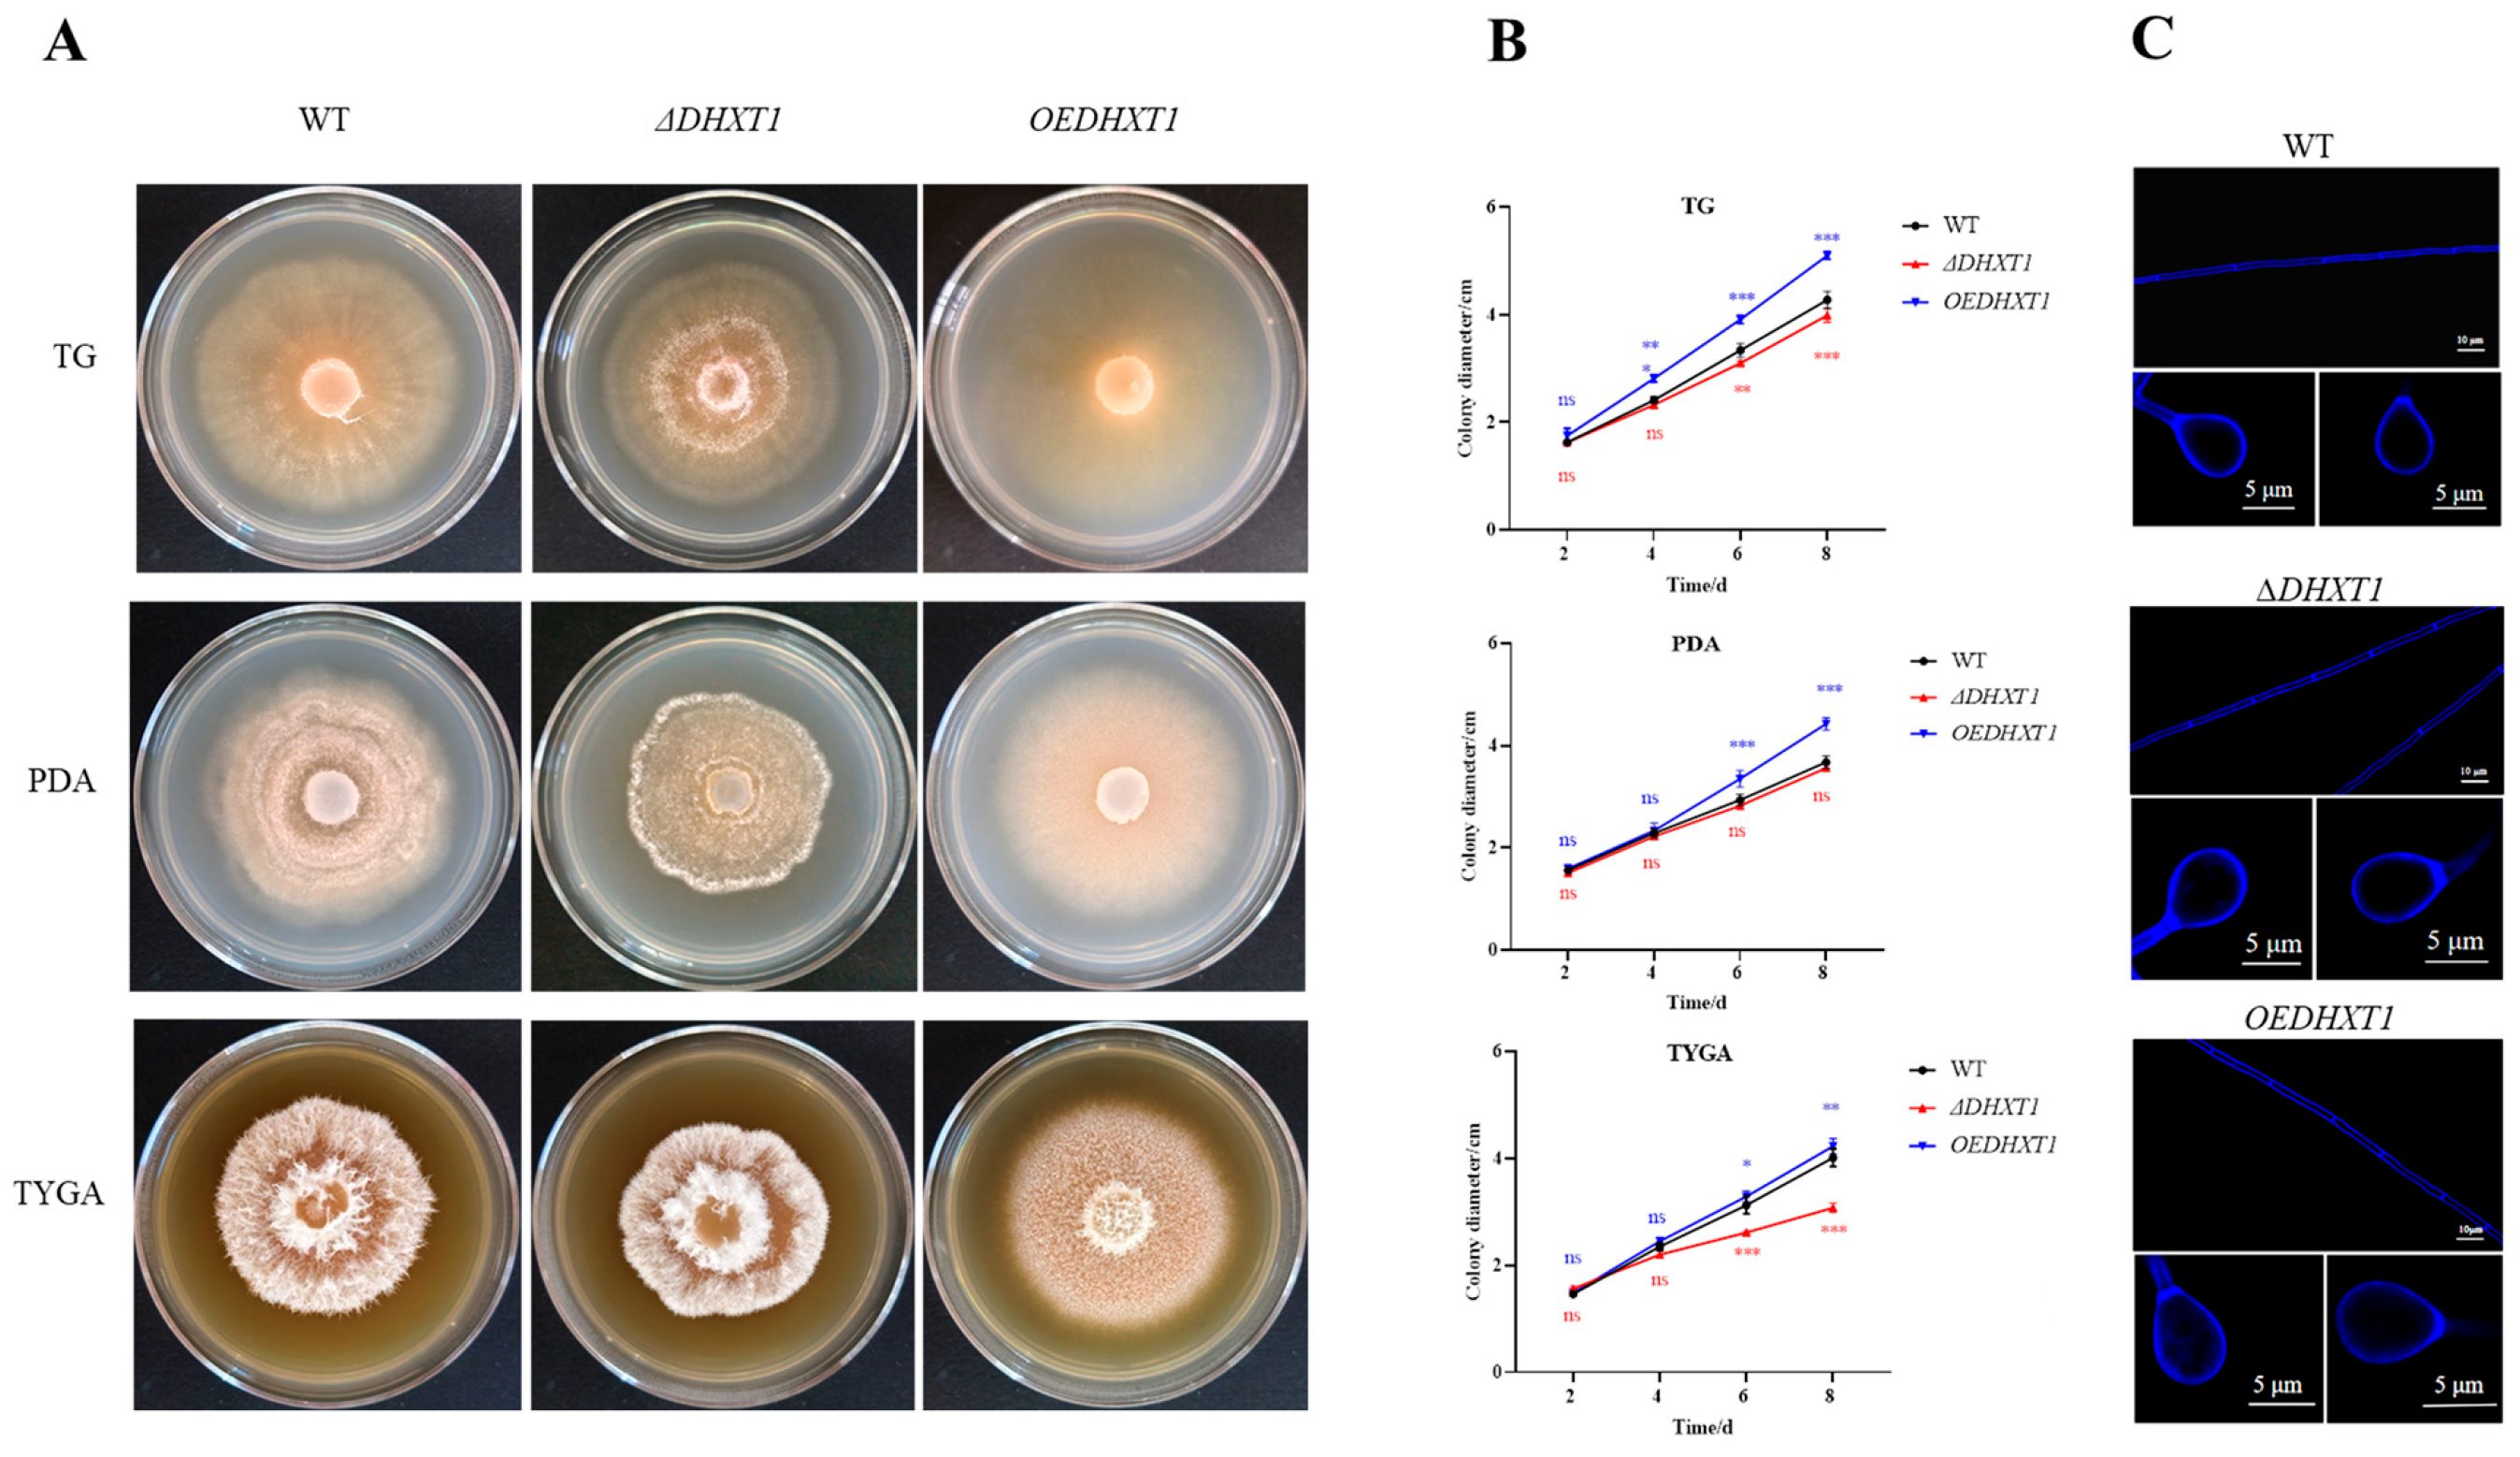
Ijms 25 07384 g001

DHXT1, a Virulence Factor of Dactylellina haptotyla, Regulates Pathogenicity by Participating in Trap Formation and Metabolite Synthesis
Abstract
1. Introduction
2. Results
2.1. Sequence and Phylogenetic Analysis of DHXT1
2.2. DHXT1 Is Involved in Mycelial Growth and Does Not Affect Conidial Germination and Mycelial and Trap Morphology
2.3. Alterations in DHXT1 Do Not Change the Resistance of D. haptotyla
2.4. DHXT1 Involved in Trap Formation and Pathogenicity
2.5. Analysis of RT-qPCR
2.6. Metabolomics Analysis of Caenorhabditis elegans Infection by D. haptotyla
3. Discussion
4. Materials and Methods
4.1. Strains and Culture Conditions
4.2. Bioinformatic and Phylogenetic Analyses of DHXT1
4.3. The Knockout and Overexpression of DHXT1
4.4. Effects of DHXT1 on Growth, Mycelial and Trap Morphology and Conidial Germination of D. haptotyla
4.5. Stress Evaluation
4.6. Determination of the Effect of DHXT1 on Trap Formation and Pathogenicity
4.7. Analysis of RT-qPCR
4.8. LC-MS Analyses and Metabolomic Data Statistical Analysis
4.9. Statistical Analyses
5. Conclusions
Supplementary Materials
Author Contributions
Funding
Institutional Review Board Statement
Informed Consent Statement
Data Availability Statement
Conflicts of Interest
References
- Nicol, J.; Turner, S.; Coyne, D.L.; Nijs, L.D.; Hockland, S.; Maafi, Z.T. Genomics molecular genetics of plant-nematode interactions. In Current Nematode Threats to World Agriculture; Jones, J., Gheysen, G., Fenoll, C., Eds.; Springer: Dordrecht, The Netherlands, 2011; pp. 21–43. [Google Scholar]
- Desaeger, J.; Wram, C.; Zasada, I. New reduced-risk agricultural nematicides-rationale and review. J. Nematol. 2020, 52, e2020-91. [Google Scholar] [CrossRef] [PubMed]
- Ahmad, G.; Khan, A.; Khan, A.A.; Ali, A.; Mohhamad, H.I. Biological control: A novel strategy for the control of the plant parasitic nematodes. Antonie Van Leeuwenhoek 2021, 114, 885–912. [Google Scholar] [CrossRef] [PubMed]
- Abd-Elgawad, M.M.M.; Askary, T.H. Fungal and bacterial nematicides in integrated nematode management strategies. Egypt. J. Biol. Pest Control 2018, 28, 74. [Google Scholar] [CrossRef]
- Khan, A.; Haris, M.; Hussain, T.; Khan, A.A.; Laasli, S.-E.; Lahlali, R.; Mokrini, F. Counter-attack of biocontrol agents: Environmentally benign Approaches against Root-knot nematodes (Meloidogyne spp.) on Agricultural crops. Heliyon 2023, 9, e21653. [Google Scholar] [CrossRef] [PubMed]
- Veenhuis, M.; Nordbring-Hertz, B.; Harder, W. Development and fate of electron-dense microbodies in trap cells of the nematophagous fungus Arthrobotrys oligospora. Antonie Van Leeuwenhoek 1985, 51, 399–407. [Google Scholar] [CrossRef]
- Dong, L.Q.; Zhang, K.Q. Microbial control of plant-parasitic nematodes: A five-party interaction. Plant Soil 2006, 288, 31–45. [Google Scholar] [CrossRef]
- Jiang, X.; Xiang, M.; Liu, X. Nematode-trapping fungi. Microbiol. Spectr. 2017, 5, funk-0022-2016. [Google Scholar] [CrossRef] [PubMed]
- Hsueh, Y.P.; Gronquist, M.R.; Schwarz, E.M.; Nath, R.D.; Lee, C.H.; Gharib, S.; Schroeder, F.C.; Sternberg, P.W. Nematophagous fungus Arthrobotrys oligospora mimics olfactory cues of sex and food to lure its nematode prey. Elife 2017, 6, e20023. [Google Scholar] [CrossRef] [PubMed]
- Yu, X.; Hu, X.; Pop, M.; Wernet, N.; Kirschhöfer, F.; Brenner-Weiß, G.; Keller, J.; Bunzel, M.; Fischer, R. Fatal attraction of Caenorhabditis elegans to predatory fungi through 6-methyl-salicylic acid. Nat. Commun. 2021, 12, 5462. [Google Scholar] [CrossRef]
- Tunlid, A.; Jansson, S. Proteases and Their Involvement in the Infection and Immobilization of Nematodes by the Nematophagous Fungus Arthrobotrys oligospora. Appl. Environ. Microbiol. 1991, 57, 2868–2872. [Google Scholar] [CrossRef]
- Åhman, J.; Ek, B.; Rask, L.; Tunlid, A. Sequence analysis and regulation of a gene encoding a cuticle-degrading serine protease from the nematophagous fungus Arthrobotrys oligospora. Microbiology 1996, 142, 1605–1616. [Google Scholar] [CrossRef] [PubMed]
- Tunlid, A.; Rosén, S.; Ek, B.; Rask, L. Purification and characterization of an extracellular serine protease from the nematode-trapping fungus Arthrobotrys oligospora. Microbiology 1994, 140, 1687–1695. [Google Scholar] [CrossRef] [PubMed]
- Song, T.-Y.; Xu, Z.-F.; Chen, Y.-H.; Ding, Q.-Y.; Sun, Y.-R.; Miao, Y.; Zhang, K.-Q.; Niu, X.-M. Potent Nematicidal Activity and New Hybrid Metabolite Production by Disruption of a Cytochrome P450 Gene Involved in the Biosynthesis of Morphological Regulatory Arthrosporols in Nematode-Trapping Fungus Arthrobotrys oligospora. J. Agric. Food Chem. 2017, 65, 4111–4120. [Google Scholar] [CrossRef] [PubMed]
- Xu, Z.-F.; Chen, Y.-H.; Song, T.-Y.; Zeng, Z.-J.; Yan, N.; Zhang, K.-Q.; Niu, X.-M. Nematicidal Key Precursors for the Biosynthesis of Morphological Regulatory Arthrosporols in the Nematode-Trapping Fungus Arthrobotrys oligospora. J. Agric. Food Chem. 2016, 64, 7949–7956. [Google Scholar] [CrossRef] [PubMed]
- Ji, X.; Yu, Z.; Yang, J.; Xu, J.; Zhang, Y.; Liu, S.; Zou, C.; Li, J.; Liang, L.; Zhang, K.-Q. Expansion of Adhesion Genes Drives Pathogenic Adaptation of Nematode-Trapping Fungi. iScience 2020, 23, 101057. [Google Scholar] [CrossRef] [PubMed]
- Yang, Y.; Yang, E.; An, Z.; Liu, X. Evolution of nematode-trapping cells of predatory fungi of the Orbiliaceae based on evidence from rRNA-encoding DNA and multiprotein sequences. Proc. Natl. Acad. Sci. USA 2007, 104, 8379–8384. [Google Scholar] [CrossRef] [PubMed]
- Liang, L.; Shen, R.; Mo, Y.; Yang, J.; Ji, X.; Zhang, K.-Q. A proposed adhesin AoMad1 helps nematode-trapping fungus Arthrobotrys oligospora recognizing host signals for life-style switching. Fungal Genet. Biol. 2015, 81, 172–181. [Google Scholar] [CrossRef] [PubMed]
- Jaffee, B.A. Correlations Between Most Probable Number and Activity of Nematode-Trapping Fungi. Phytopathology 2003, 93, 1599–1605. [Google Scholar] [CrossRef][Green Version]
- Jaffee, B.A. Do organic amendments enhance the nematode-trapping fungi Dactylellina haptotyla and Arthrobotrys oligospora? J. Nematol. 2004, 36, 267–275. [Google Scholar]
- Lei, H.-M.; Lei, H.-M.; Wang, J.-T.; Wang, J.-T.; Hu, Q.-Y.; Hu, Q.-Y.; Li, C.-Q.; Li, C.-Q.; Mo, M.-H.; Mo, M.-H.; et al. 2-Furoic acid associated with the infection of nematodes by Dactylellina haptotyla and its biocontrol potential on plant root-knot nematodes. Microbiol. Spectr. 2023, 11, e0189623. [Google Scholar] [CrossRef]
- Lei, H.; Zhang, G.; Zhao, P.; Li, G. Secondary Metabolites from the Nematode-Trapping Fungus Dactylellina haptotyla YMF1.03409. Microorganisms 2023, 11, 2693. [Google Scholar] [CrossRef]
- Okabayashi, K.; Hasegawa, A.; Watanabe, T. Microreview: Capsule-associated genes of Cryptococcus neoformans. Mycopathologia 2007, 163, 1–8. [Google Scholar] [CrossRef] [PubMed]
- Chang, Y.C.; Kwon-Chung, K.J. Isolation, Characterization, and Localization of a Capsule-Associated Gene, CAP10, of Cryptococcus neoformans. J. Bacteriol. 1999, 181, 5636–5643. [Google Scholar] [CrossRef] [PubMed]
- Grijpstra, J.; Gerwig, G.J.; Wösten, H.; Kamerling, J.P.; de Cock, H. Production of Extracellular Polysaccharides by CAP Mutants of Cryptococcus neoformans. Eukaryot. Cell 2009, 8, 1165–1173. [Google Scholar] [CrossRef] [PubMed]
- Klutts, J.S.; Levery, S.B.; Doering, T.L. A β-1,2-Xylosyltransferase from Cryptococcus neoformans Defines a New Family of Glycosyltransferases. J. Biol. Chem. 2007, 282, 17890–17899. [Google Scholar] [CrossRef]
- Acar, M.; Jafar-Nejad, H.; Takeuchi, H.; Rajan, A.; Ibrani, D.; Rana, N.A.; Pan, H.; Haltiwanger, R.S.; Bellen, H.J. Rumi Is a CAP10 Domain Glycosyltransferase that Modifies Notch and Is Required for Notch Signaling. Cell 2008, 132, 247–258. [Google Scholar] [CrossRef]
- Tefsen, B.; Grijpstra, J.; Ordonez, S.; Lammers, M.; van Die, I.; de Cock, H. Deletion of the CAP10 gene of Cryptococcus neoformans results in a pleiotropic phenotype with changes in expression of virulence factors. Res. Microbiol. 2014, 165, 399–410. [Google Scholar] [CrossRef]
- Tunlid, A.; Johansson, T.; Nordbring-Hertz, B. Surface polymers of the nematode-trapping fungus Arthrobotrys oligospora. J. Gen. Microbiol. 1991, 137, 1231–1240. [Google Scholar] [CrossRef]
- Lin, H.-C.; de Ulzurrun, G.V.-D.; Chen, S.-A.; Yang, C.-T.; Tay, R.J.; Iizuka, T.; Huang, T.-Y.; Kuo, C.-Y.; Gonçalves, A.P.; Lin, S.-Y.; et al. Key processes required for the different stages of fungal carnivory by a nematode-trapping fungus. PLOS Biol. 2023, 21, e3002400. [Google Scholar] [CrossRef]
- Livak, K.J.; Schmittgen, T.D. Analysis of relative gene expression data using real-time quantitative PCR and the 2−ΔΔCT Method. Methods 2001, 25, 402–408. [Google Scholar] [CrossRef]

Disclaimer/Publisher’s Note: The statements, opinions and data contained in all publications are solely those of the individual author(s) and contributor(s) and not of MDPI and/or the editor(s). MDPI and/or the editor(s) disclaim responsibility for any injury to people or property resulting from any ideas, methods, instructions or products referred to in the content. |
© 2024 by the authors. Licensee MDPI, Basel, Switzerland. This article is an open access article distributed under the terms and conditions of the Creative Commons Attribution (CC BY) license (https://creativecommons.org/licenses/by/4.0/).
Share and Cite
Wen, X.-F.; Shi, T.-T.; Zhang, Y.-Q.; Wang, S.-H.; Xiang, C.-M.; Zhao, P.-J. DHXT1, a Virulence Factor of Dactylellina haptotyla, Regulates Pathogenicity by Participating in Trap Formation and Metabolite Synthesis. Int. J. Mol. Sci. 2024, 25, 7384. https://doi.org/10.3390/ijms25137384
Wen X-F, Shi T-T, Zhang Y-Q, Wang S-H, Xiang C-M, Zhao P-J. DHXT1, a Virulence Factor of Dactylellina haptotyla, Regulates Pathogenicity by Participating in Trap Formation and Metabolite Synthesis. International Journal of Molecular Sciences. 2024; 25(13):7384. https://doi.org/10.3390/ijms25137384
Chicago/Turabian StyleWen, Xing-Fu, Ting-Ting Shi, Ya-Qi Zhang, Si-Han Wang, Chun-Mei Xiang, and Pei-Ji Zhao. 2024. "DHXT1, a Virulence Factor of Dactylellina haptotyla, Regulates Pathogenicity by Participating in Trap Formation and Metabolite Synthesis" International Journal of Molecular Sciences 25, no. 13: 7384. https://doi.org/10.3390/ijms25137384
APA StyleWen, X.-F., Shi, T.-T., Zhang, Y.-Q., Wang, S.-H., Xiang, C.-M., & Zhao, P.-J. (2024). DHXT1, a Virulence Factor of Dactylellina haptotyla, Regulates Pathogenicity by Participating in Trap Formation and Metabolite Synthesis. International Journal of Molecular Sciences, 25(13), 7384. https://doi.org/10.3390/ijms25137384

